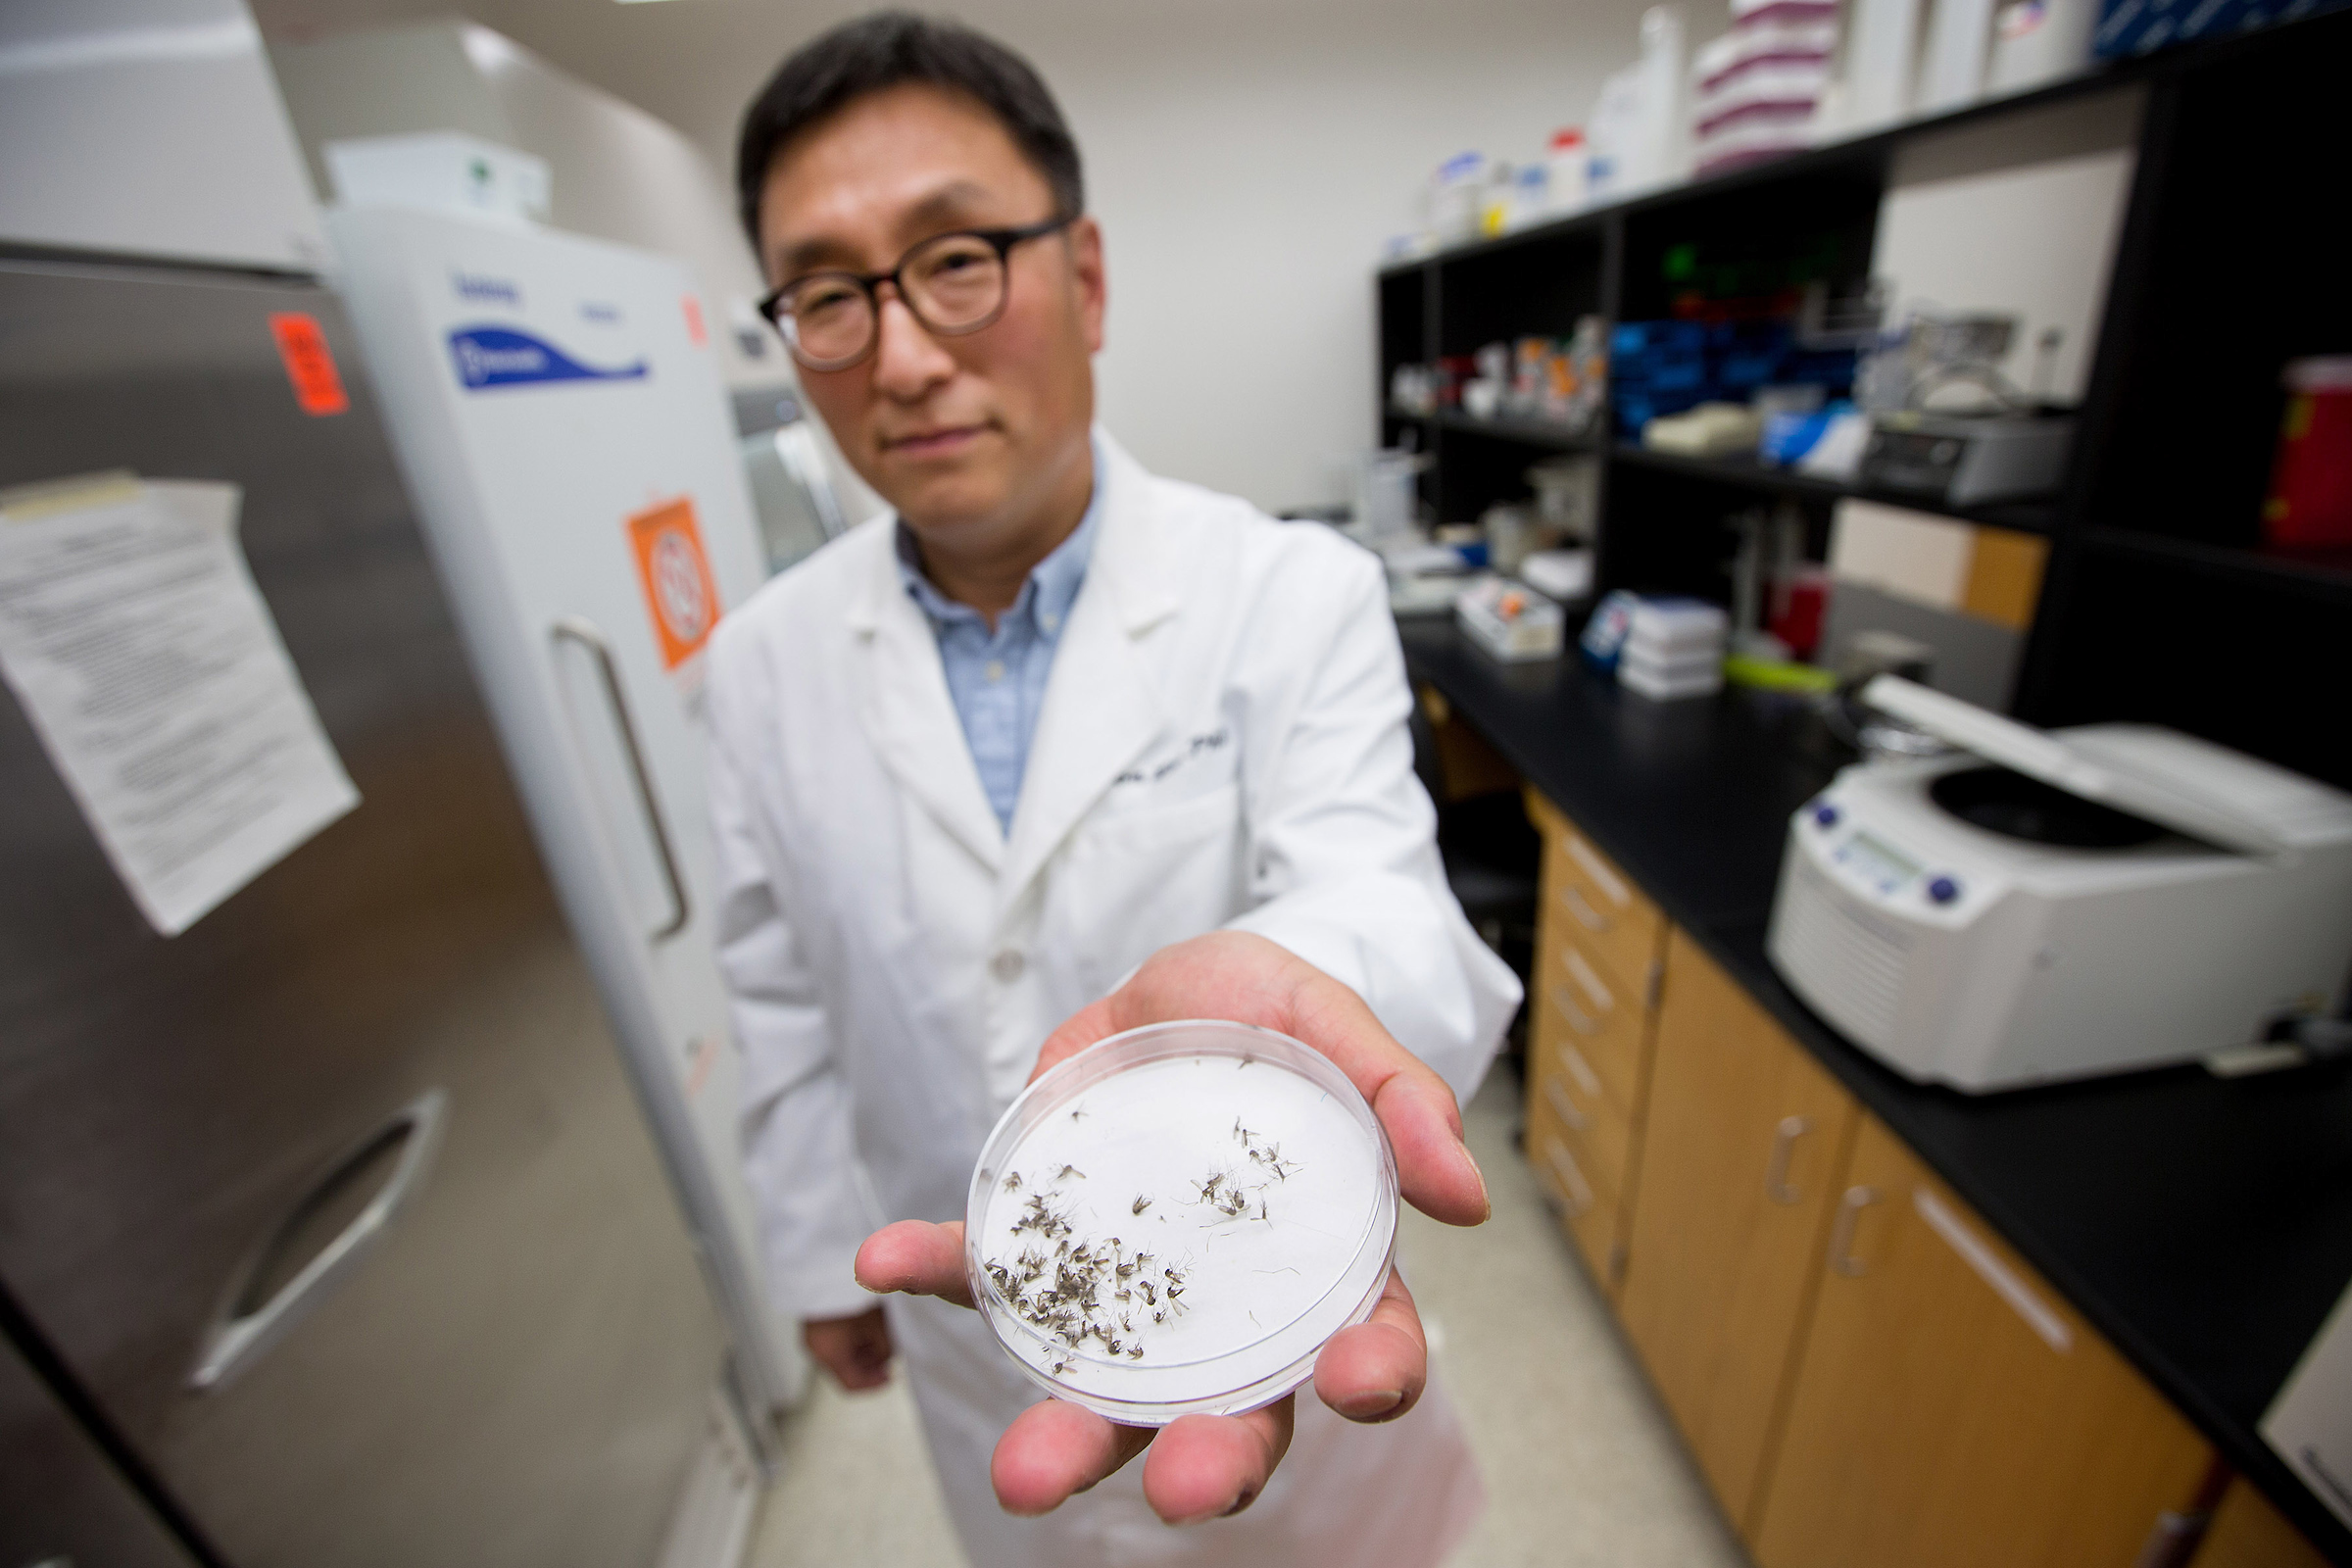
UNT Health Stock 054

Office of Institutional Advancement
Creating healthier communities together
With your support our schools, research and special programs are able to meet their goals of providing solutions for healthier communities, fulfilling the institution’s commitment for values-based and patient-focused education, discovery and health care.

People
Our students are changing the world. Give now to support scholarships and student success.
Support our students
Programs and Research
Your gift in support of UNT Health research projects can make an exponential impact.
Support our programs and research
Community
Support our efforts to prevent diseases through research and community outreach.
Support our community outreach
